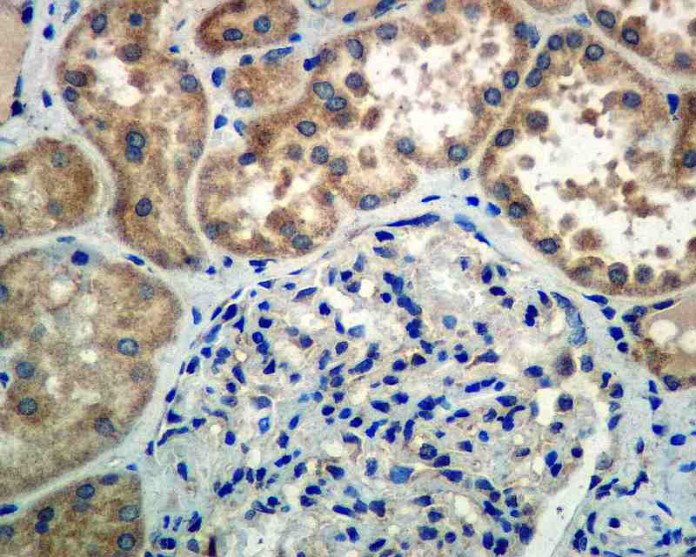

Los investigadores de Leuven (VIB / KU Leuven) han confirmado su hipótesis de que la normalización de los vasos sanguíneos por PHD2 con un bloqueo de sensor de oxígeno podría hacer que la quimioterapia sea más eficaz. También se ha demostrado por primera vez que esta estrategia podría reducir los efectos secundarios nocivos de la quimioterapia en los órganos sanos.
La eficacia de la quimioterapia es, ante todo, limitada por las dificultades de la entrega de los medicamentos contra el cáncer en el tumor real.
Los tumores se caracterizan por los vasos sanguíneos de forma anormal – que son de forma irregular – o que tienen texturas débiles y desgarra con facilidad. Estos vasos sanguíneos dañados impiden que las drogas contra el cáncer lleguen a las células tumorales, mientras que promocionan la metástasis. En segundo lugar, la quimioterapia puede tener efectos nocivos sobre los órganos sanos, lo que lleva incluso al corazón e insuficiencia renal.
Las investigaciones anteriores en el laboratorio de Max Mazzone ya habían demostrado que la actividad reducida de la PHD2 sensor de oxígeno bajo condiciones de hipoxia como resultado una vascularización más ágil.
En este nuevo estudio, y utilizando modelos de ratón, de Rodrigo Leite de Oliveira, Deschoemaker Sofie y Mazzone Max probaran su hipótesis anterior de que la racionalización del flujo sanguíneo por la inhibición de PHD2 puede hacer que los tratamientos del cáncer más eficaces. En primer lugar, los vasos sanguíneos mejor formados asegurar que los medicamentos contra el cáncer se distribuyen por todo el tumor, aumentando así su impacto.
También permiten dosis más pequeñas – una ventaja significativa cuando se administran fármacos tóxicos.
Los investigadores aún demonstraran que la inhibición de PHD2 resulta en la producción de enzimas antioxidantes capaces de neutralizar los efectos secundarios nocivos de la quimioterapia.
El estudio es prometedor: la quimioterapia combinada con inhibidores específicos PHD2 haría la quimioterapia más eficaz al tiempo que reduce los efectos secundarios dañinos que ponen como una pesada carga para los pacientes.
Desafortunadamente, no existen inhibidores específicos PHD2 disponibles en este momento, así que tenemos un largo camino por recorrer antes de que los pacientes podrán beneficiarse de este descubrimiento.
articulos cientificos quimioterapia y onicodistrofia






